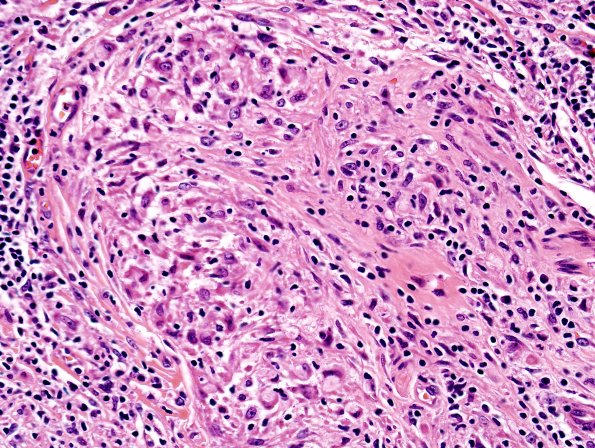
3A10 Leprosy, tuberculoid (Case 3) H&E 3

Table of Contents
Washington University Experience | PERIPHERAL NEUROPATHY | 10 INFECTION | 4 Leprosy – Tuberculoid | 3A10 Leprosy, tuberculoid (Case 3) H&E 3
The axons were essentially absent in the presence of well formed granulomas composed of lymphocytes and epithelioid histiocytes with relatively few multinucleated giant cells. (H&E)